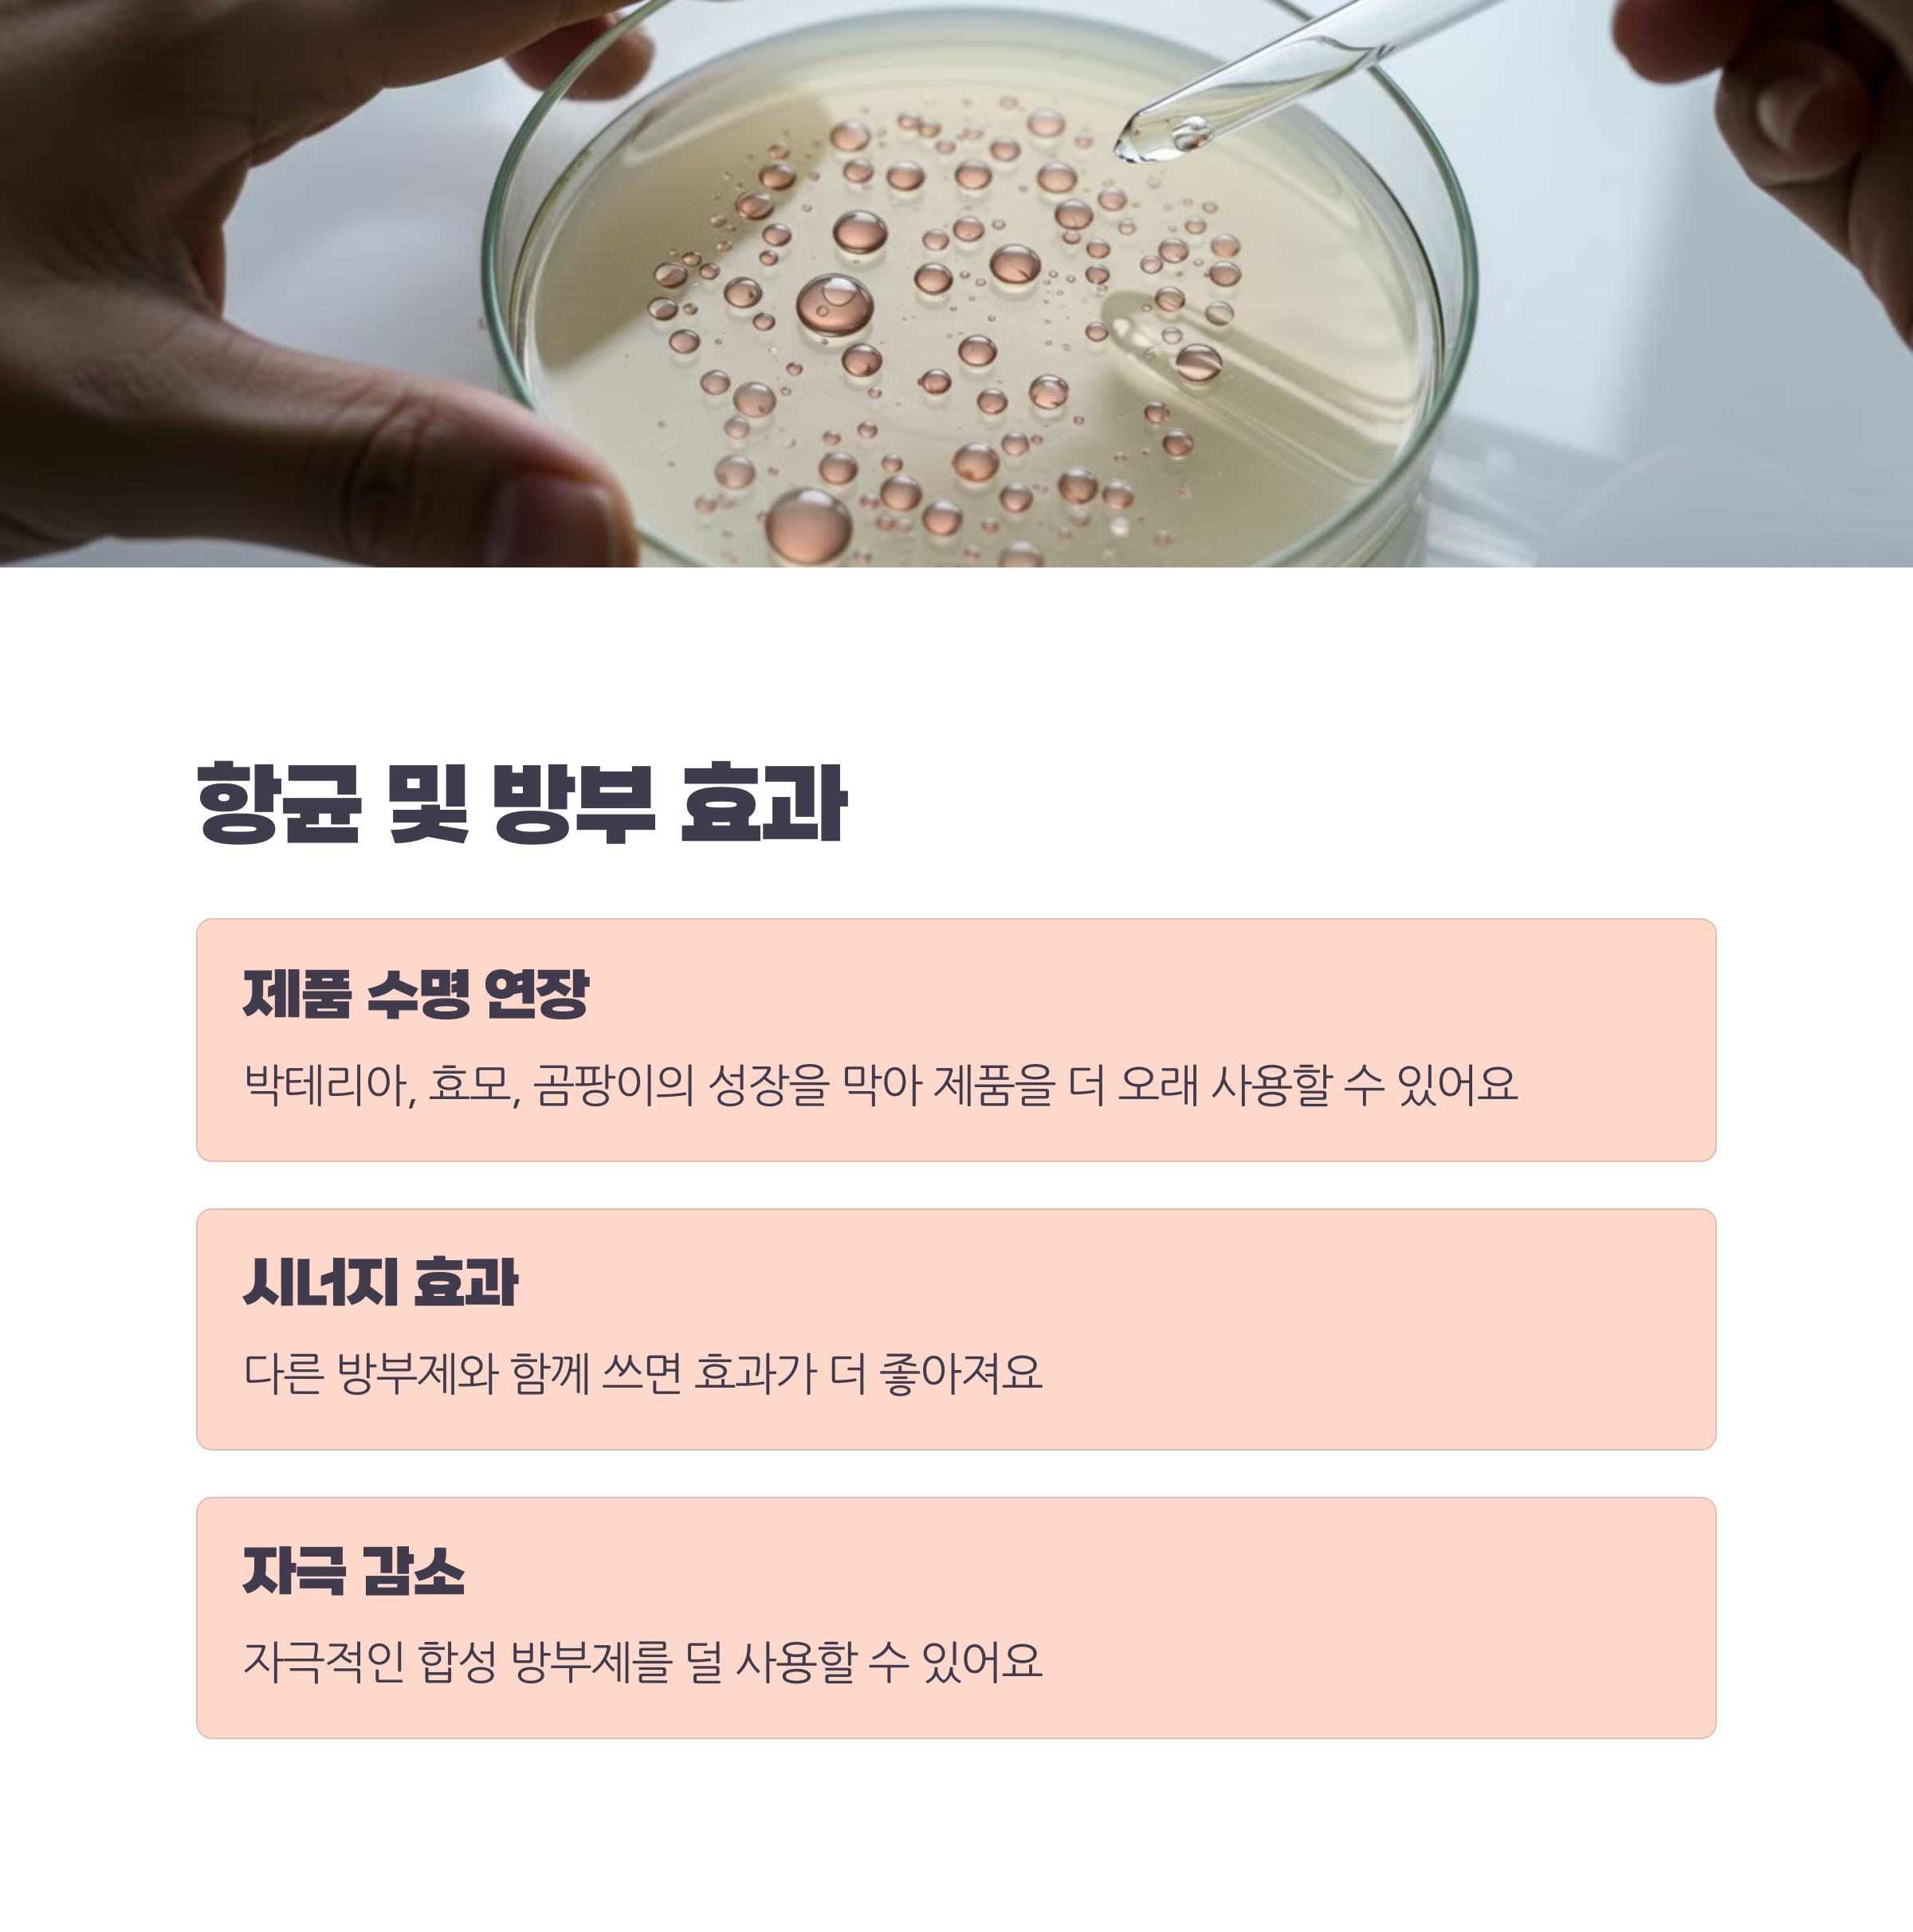

바쁜 일상 속에서 화장품을 고를 때 성분표를 꼼꼼히 확인하시나요?
오늘은 많은 화장품에 들어있지만 잘 알려지지 않은 성분, 카프릴릴글라이콜에 대해 알아볼게요.
이 성분은 단순한 방부제 역할을 넘어 피부 건강에 다양한 혜택을 제공하는 다재다능한 성분이랍니다!
카프릴릴글라이콜이란?
카프릴릴글라이콜은 반고체에서 흰색 고체 상태의 물질로, 화장품 업계에서 다양한 목적으로 사용되고 있어요. 주로 보습제, 유화제, 그리고 방부제로서 세 가지 주요 기능을 가지고 있답니다.
화학적 특성
카프릴릴글라이콜은 특별한 화학 구조 덕분에 효과적인 수분 공급과 화장품 제형의 안정화에 도움을 줘요.
이런 특성 때문에 스킨케어와 헤어케어 제품에서 정말 가치 있는 성분으로 인정받고 있답니다.
카프릴릴글라이콜의 주요 효능
1. 뛰어난 보습 효과
카프릴릴글라이콜은 수분을 끌어당기고 피부에 머물게 해서 촉촉함을 유지시켜 줘요. 특히 건조하거나 탈수된 피부에 정말 좋답니다.
- 수분을 끌어당겨 피부에 촉촉함을 더해줘요
- 수분이 날아가지 않도록 막아주는 역할을 해요
- 피부 탄력을 높이고 건조함을 예방해줘요
2. 항균 및 방부 효과
카프릴릴글라이콜은 항균 특성이 있어서 화장품의 자연 방부제 역할을 해요.
박테리아, 효모, 곰팡이의 성장을 막아 제품이 오래 신선하게 유지될 수 있도록 도와줍니다.
- 제품을 더 오래 사용할 수 있어요
- 다른 방부제와 함께 쓰면 효과가 더 좋아져요
- 자극적인 합성 방부제를 덜 사용할 수 있어요
3. 노화 방지 효과
카프릴릴글라이콜의 뛰어난 보습 능력은 노화 징후를 줄이는 데 한몫해요.
나이가 들면서 피부가 수분을 잃게 되면 처짐, 주름, 잔주름이 생기기 쉽거든요.
카프릴릴글라이콜이 피부에 수분을 공급해서 이런 노화 징후를 완화하는 데 도움을 준답니다.
4. 제품 텍스처 개선
카프릴릴글라이콜은 화장품이 피부에 더 부드럽고 고르게 발리도록 도와줘요.
덕분에 제품의 커버력도 좋아지고, 사용감도 더 좋아진답니다.
카프릴릴글라이콜이 사용되는 제품들
카프릴릴글라이콜은 정말 다양한 화장품과 개인 관리 제품에서 만나볼 수 있어요:
- 스킨케어 제품: 모이스처라이저, 로션, 세럼, 마스크
- 헤어케어 제품: 샴푸, 컨디셔너
- 메이크업 제품: 파운데이션, 브론저, 립스틱
- 선케어 제품: 자외선 차단제
- 클렌징 제품: 클렌저, 메이크업 리무버
카프릴릴글라이콜의 안전성
카프릴릴글라이콜은 대체로 안전한 성분으로 알려져 있어요. 민감한 피부를 가진 분들도 사용하기에 적합하답니다.
실제로 많은 사람들을 대상으로 한 테스트에서도 별다른 문제가 없었다고 해요.
- 민감한 피부에도 잘 맞아요
- 자극 가능성이 낮아요
- 화장품의 안정성을 높여줘요
카프릴릴글라이콜을 활용한 스킨케어 팁
1. 건조한 피부를 위한 선택
건조하거나 수분이 부족한 피부라면 카프릴릴글라이콜이 들어간 보습 제품을 써보세요.
피부에 수분을 채워주고 유지시켜서 건조함과 당김을 줄여줄 거예요.
2. 민감한 피부를 위한 대안
민감한 피부 때문에 자극적인 방부제가 적은 제품을 찾고 계셨다면, 카프릴릴글라이콜이 들어간 제품을 한번 써보세요.
다른 방부제의 효과를 높여주어 전체적인 방부제 사용량을 줄일 수 있어 좋답니다.
3. 복합성 피부를 위한 제품 선택
카프릴릴글라이콜은 가볍고 모공을 막지 않는 특성이 있어서 지성이나 여드름 피부를 포함해 모든 피부 타입에 잘 맞아요.
마무리
카프릴릴글라이콜은 보습, 방부, 텍스처 개선 등 다양한 효능을 가진 다재다능한 화장품 성분이에요.